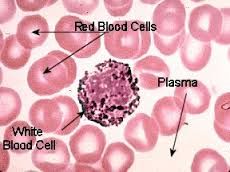
230x172 Best Chapter Histology Images Human Anatomy, Anatomy - Blood Tissue Drawing

Blood Tissue Drawing
Are you looking for the best images of Blood Tissue Drawing? Here you are! We collected 37+ Blood Tissue Drawing paintings in our online museum of paintings - PaintingValley.com.
Most Downloads Size Popular
Views: 4070 Images: 37 Downloads: 4 Likes: 0

Biology Summer Assig...
720x504 2 0

Best How To Wounds, ...
236x236 1 0

Blood Texas Heart In...
250x237 1 0

Cells, Tissues Organ...
1491x1779 0 0

Organ Drawing Human ...
728x942 0 0

Lymphatic System Wor...
600x669 0 0
Best Chapter Histolo...
230x172 0 0

Epithelial Tissue An...
937x1502 0 0

Connective Tissue Su...
1439x760 0 0

A Cross Sectional Vi...
283x283 0 0

Anatomy And Physiolo...
636x266 0 0

Animal Primary Tissu...
1117x581 0 0

Animal Tissues Plant...
261x219 0 0

Animal Tissues Plant...
899x785 0 0

Blood Samples Cartoo...
400x267 0 0

Blood Tissue Nematod...
358x270 0 0

Clock Drawing Cognit...
800x480 0 0

Components Of Blood ...
1575x1213 0 0

Connective Tissue An...
960x1135 0 0

Cord Blood Banking V...
800x229 0 0

Drawing Lab Histolog...
960x720 0 0

Definition Of Soft T...
750x613 0 0

Drawing Showing Coro...
501x298 0 0

Google Filed Patent ...
600x450 0 0

Help I Need A Tissue...
1080x1080 0 0

Human Anatomy Blood ...
493x335 0 0

Lab Drawings - Blood...
755x507 0 0

Ocr As Biology Hard ...
1280x720 0 0

Ppt - Blood Tissue D...
720x540 0 0

Schematic Drawing Of...
850x1518 0 0

Sketch Your Neurosci...
753x423 0 0

The Histology Guide ...
300x275 0 0

The Project Gutenber...
480x312 0 0

The Human Circulator...
200x456 0 0

Tissues - Blood Tiss...
1024x768 0 0

Types Of Connective ...
295x195 0 0

What Are Blood Vesse...
1000x687 0 0
All rights to paintings and other images found on PaintingValley.com are owned by their respective owners (authors, artists), and the Administration of the website doesn't bear responsibility for their use. All the materials are intended for educational purposes only. If you consider that any of the materials violates your rights, and you do not want your material to be displayed on this website, please get in touch with us via "contact us" page and your copyrighted material will be immediately removed.



















